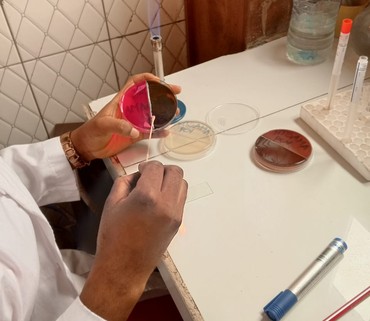
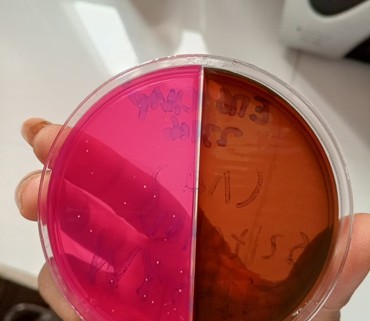
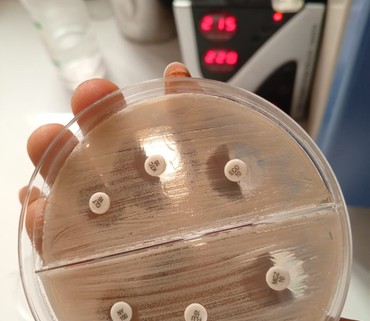

Bilan prenatal disponible chez DIP'S LAB
DIP'S LAB propose un bilan prenatal a 30 000 F regroupant plusieurs examens utiles au suivi de grossesse. L'offre visible sur les supports de communication comprend notamment l'electrophorese, la glycemie a jeun, le groupe sanguin, la toxoplasmose, la goutte epaisse, les hepatites B et C, la rubeole ainsi que le TP/TCK.
Une formule claire pour mieux suivre la grossesse
L'objectif de ce bilan est de faciliter l'acces a plusieurs examens dans une seule offre, afin d'aider les patientes a mieux organiser leur suivi prenatal. Cette presentation simple permet aussi de comprendre rapidement la valeur du pack et les analyses incluses.
En communiquant de cette facon, DIP'S LAB montre une approche pratique, lisible et orientee vers l'accompagnement quotidien des patients.

Le bilan prenatal fait partie des prestations qui renforcent la position du laboratoire comme structure de proximite a Yaounde, avec des services cibles et un contact WhatsApp direct pour toute information.

Commentaires (37)
"Le service est clair, l'accueil est rassurant et les resultats inspirent confiance."
REPONDRE"Le service est clair, l'accueil est rassurant et les resultats inspirent confiance."
REPONDRELAISSER UN MESSAGE